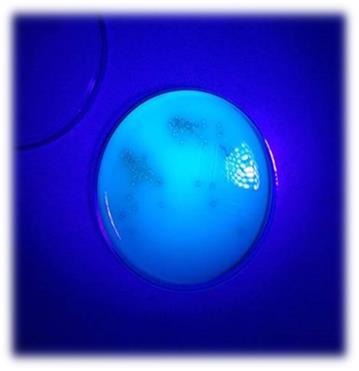
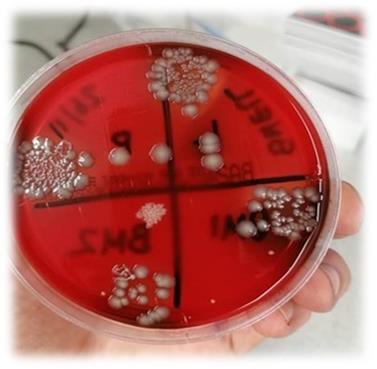

May 2022
Here is the latest from the Mount Vets team; if you have any stories or news that you would like to see included in our next newsletter, please email nicole.jales@mountvetsfarmpractice.com
We want to hear your feedback… Leave us a review!
We aim to give the best service possible and value your feedback. We would appreciate if you could take the time to give us a review, we’d love to hear your thoughts! Please click the link below.
Changes to TB testing after slaughterhouse cases
From the end of March 2022, APHA is now using PCR tests to confirm the presence of M. bovis in TB-like lesions found slaughterhouse cases of TB. Previously, bacterial culture was the preferred method of confirmation which could take 6-22 weeks. This meant that livestock keepers were kept in the dark for a potentially long time after the discovery of lesions in the slaughterhouse.
This new PCR testing will reduce the confirmation time down to 3 weeks, which may lead to movement restrictions being lifter sooner if the testing returns a negative result. This new testing is not going to be used in TB reactors found on farm at present, but APHA have said this may happen in the future depending on the performance in slaughterhouse cases.
If there are any further questions regarding this change, please contact one of our TBAS Advisers at the practice. We are always happy to talk about TB.
Our TBAS Advisers in practice are:

Ollie

Tony

David
Upcoming courses

MASTERING MEDICINES
28TH JUNE 2022 12-3 PM
Only 2 more spaces are available
 The Farm Assurance Guidelines have changed. It is now recommended that at least one team member responsible for administering medicines has undertaken training and holds a certificate of competence. Attending our Mastering Medicines course ensures you are compliant with this recommendation. £50 + VAT.
The Farm Assurance Guidelines have changed. It is now recommended that at least one team member responsible for administering medicines has undertaken training and holds a certificate of competence. Attending our Mastering Medicines course ensures you are compliant with this recommendation. £50 + VAT.


FOOT TRIMMING
26th JULY 10.30am-4pm
Only 2 more spaces are available
The Farm Assurance Guidelines have changed. It is now recommended that at least one team member responsible for administering medicines has undertaken training and holds a certificate of competence. Attending our Mastering Medicines course ensures you are compliant with this recommendation. £50 + VAT.


BE A BETTER HERDSPERSON COURSE
BEGINS 21st SEPTEMBER 2022
Are you a young farmer or farm worker with a growing interest in dairy cows?
This course has been designed for those who are keen to improve their ability to assist in the health management of a modern dairy herd. It is very much a” hands on” course and sets out to increase understanding of the cow & her environment, show best practice, common pitfalls and aims to teach skills that can be used by anyone on a daily basis to help improve cow health and performance.
The course consists of six modules run between 11am & 3:30pm, once a week, every Wednesday (except for one week, which will run on Thursday 13th October)We even provide drinks, snacks, and lunch!
Modules include:
- Calving & Newborn
- Calves & Youngstock
- Milking & Mastitis
- Improving Fertility
- Nutrition
- Lameness & Housing
This course will cost £200 for YFC age. The low price is made possible by funding from The Laura Persey Trust. Anyone above YFC age is welcome to join but will be charged the unsubsidised fee of £500.
Please ring Nicole to book your place on any of our courses on 07587054487 or email nicole.jales@mountvetsfarmpractice.com
Calf Health Forum

We held our first Calf Health Forum meet up on the 24th of May.
Following on from our Calf Health Forum series, which ran during April & May, we invited attendees from past and present to join us in a Calf Health Group get together.
We previously held our Calf Health Forum in 2018, so it was great to see so many of you joining us from the previous course. Time has flown.
Our Vets Rob and Stuart were there to discuss more Calf Health topics; which gave everyone the opportunity to have their questions answered. It was great for everyone to get together to share advice and knowledge.
The evening was kindly sponsored by Boehringer Ingelheim.
If you would like to find out more or if you would like to be added to the waiting list for the next Calf Health Forum please email: nicole.jales@mountvetsfarmpractice.com
Lungworm
With the grazing season in full swing, we may soon start seeing cases of Lungworm cropping up in cattle. The main risk period is between July and October, and grazing seasons can have more favourable conditions for the parasite leading to variation in severity between years.

Cause
Bovine lungworm is caused by the parasite Dictyocaulus viviparus and is also known as “Husk”. Infective larvae are eaten by cattle and then migrate through the gut to reside as adults in the lungs and airways. This migration causes damage leading to the clinical signs shown by infected cattle. The adult lungworm produces eggs which are coughed up and swallowed. The eggs hatch inside the gut of the cow and are passed out as larvae onto the pasture. These larvae then develop into their infective stage very quickly and can lead to rapid contamination of the pasture.
Clinical Signs and Diagnosis
Lungworm is most commonly seen in first season grazers with no prior exposure but should be considered in any cattle out at grass who are showing signs of a persistent cough. Early signs include coughing after exercise and an increased breathing rate. This may develop into coughing even when resting, loss of condition and milk drop in dairy cows. If animals with no immunity are exposed to pasture with high levels of contamination, sudden death can occur.
We can diagnose Lungworm on dung samples, it is a different technique to a normal worm egg count that we can run overnight or send off to our external laboratory. A glove full of fresh dung is a good sample size.
A presumptive diagnosis can also be reached based on farm history, clinical signs being shown and response to treatment. Lungworm larvae can also be found in the airways of dead animals

Treatment
Most of the wormers in use at the moment are effective against Lungworm in the UK, these include the yellow and clear drenches. Where there is an outbreak in a group, all animals within that group should be treated. Animals showing signs of severe respiratory distress should be examined by a vet before treatment. Treatment of animals with heavy burdens can lead to mass die off and a large inflammatory response. We can mitigate this by treating with anti-inflammatories such as Metacam or a steroid alongside the wormer if necessary.
Prevention
Where the is no history of Lungworm on farm, care should be taken to avoid introducing it with bought in animals. There should be a quarantine protocol in place, where bought in animals are isolated from home stock and treated with an effective wormer before being introduce to clean pasture.
On farms with a history of Lungworm, vaccination can be an effective method of control. First season grazers should receive a course of vaccination before turnout to provide protection for the grazing season. Second season grazers can also be affected if they were not exposed during their first grazing season and therefore did not develop any immunity.
The Lungworm vaccine that we currently stock is Huskvac (MSD). This is an oral vaccine that can be used on calves older than 8 weeks and requires two doses, 4 weeks apart.

What is the role of ‘Diagnostics’ in Mastitis Reduction, Treatment Selection and Antibiotic Justification?
Mastitis reduction is a huge challenge, and most successfully achieved when farmers and vets unite to look at the problem holistically. Below is a little snippet of how mastitis bug diagnostics have moved on and could be used to help in this fight.
 On-Farm Mastitis Tests
On-Farm Mastitis Tests
These tests have improved a lot and although they cannot promise 100% accuracy, they play a big role in antibiotic reduction and targeting of treatments. We have moved to a far simpler and cheaper kit called VetoSlide (replacing MastDecide). In essence, bacteria that grow after 24hrs on the green side of the kit are unlikely to need antibiotic therapy, while bacteria grown on the red side may benefit from antibiotic therapy. When implementing an on-farm mastitis culture kit protocol, good discussion with your lead vet will allow you to assess the suitability to your dairy. The kits are cheaper than a course of tubes and advised to be used on each case of clinical mastitis. These kits will become increasingly relevant as farmers, vets, consumers and milk-buyers align in their desires to only use antibiotics where necessary.
So, do we still need to culture milk samples in a laboratory?
We feel the answer is ‘yes’. At our in-house laboratory, we can specifically identify many of these bugs, helping you make more informed decisions about how to treat and prevent mastitis. Milk cultures can tell us helpful information on high cell count cows as well, which an on-farm culture would not. The power of understanding the profile of bugs on-farm is the direction this gives us in our plan of attack to prevent mastitis. We always wish to choose prevention over cure. Laboratory culture also has roles in simple clinical cases, where we challenge the bugs against antibiotics, to help infer the best type of antibiotic to use when antibiotic treatment is unavoidable. Similarly, we can culture samples after treatment to provide confidence in the completeness of cure.
Results can take up to 3 days; we will then discuss the results with you to get the most out of the investigation. Our team can guide you on taking a sterile milk sample and submitting it to the lab for culture.
So as we can see, while on-farm cultures can help with individual treatment decisions, lab-based milk cultures are still a crucial part of formulating the farm-wide assault on mastitis. Our vets would love to discuss the use of these technologies on your farm. We see them as an inevitable part of your mastitis protocols with milk-buyers’ increasing focus on treatment justification.
If you need any advice, contact our team on 01823 663384
Have a question about any of the topics covered in this newsletter?
If you need any assistance with the topics covered in this newsletter, please do not hesitate to get in touch with our experienced farm vets who will be able to help. Call 01823 663384, or contact us here.